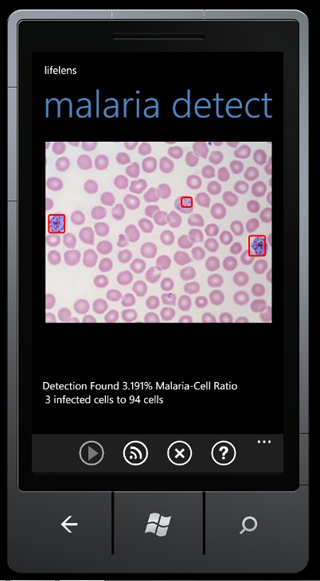

|
Detecting Malaria Via Virtual Microscopes April 11, 2011 | WMFE - A UCF graduate student has created a software application that turns smart phones into virtual microscopes that can detect malaria. He and his team members will find out today whether their "app" will move on to the next level of an international competition that could help them develop and market the product. Instead of placing a human blood sample under a microscope in a lab, the new software lets you take a digital snapshot of the sample and run it through a Windows phone app. In a few moments, the software will tell you if the patient has malaria. The only preparation necessary is to place a drop of dye in the blood sample – that's the same way it’s done in a lab. UCF graduate student Tristan Gibeau developed the software. He hopes it will make it easier and cheaper for health workers in remote areas to test for blood diseases. "It was really just to try to help save as many people and try to literally try to create a new creative edge or new technology edge to how it’s being done now to make it safer and more reliable," Gibeau said. His application is a finalist in Microsoft’s 2011 Imagine Cup competition. The winners get money to develop their product and potentially take it to market. Gibeau says investors have already approached him for possible pilot studies of the technology in India and Africa.
|
|
|